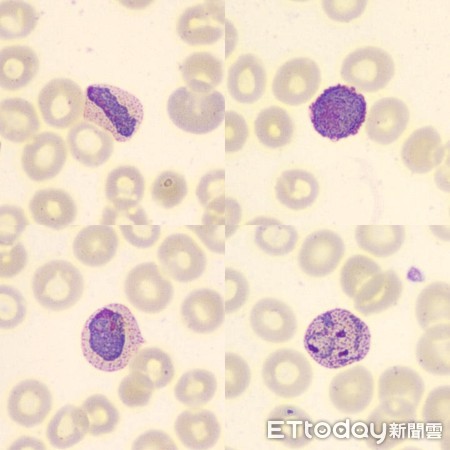
▲間日瘧。(圖/疾管署提供)

▲ AI人工智慧揪出瘧疾,疾管署「鷹眼專家」終能退休了。(攝影/劉亮亨、莊喬迪、張凱喨;製作/張舒芸;資料提供/疾管署)
記者嚴云岑/專訪
「那年我才18歲,只覺得有工作就來了,沒想到一做就46年多。」現年66歲的郭明珠是全台瘧疾判讀第一人,被疾管署同仁譽為「鷹眼」,醫院送來的影像檔或血片,只要在顯微鏡下看一眼就能揪出帶原。她笑著分享研判秘訣,自謙表示「就是靠經驗」。即將退休的她,很高興疾管署創新用人工智慧分擔重任,退休後若有餘裕,也願意回鍋指導,為台灣防瘧再盡心力。
郭明珠是檢驗及疫苗研製中心寄生蟲實驗室辦事員,民國60年以臨時雇員的身份,進到「瘧疾研究中心」,被分配到人體血液寄生研究工作,月薪僅1000元,直至民國80多年轉為正式雇員,月薪才達到正常水準。由於瘧疾已於民國54年根除,18歲的她馬上面臨兩項難題,一為業務縮編,二為世代斷層。
郭明珠笑稱,當年傳承經驗的前輩至少都與她相差20歲,「剛好是一個世代」,整個研究中心也為了這個小姑娘開設「一人訓練班」,教導認識疾病、瘧原蟲與顯微鏡實作,只花了1個月訓練,就讓她親上火線,判讀醫院送來的血片是否有瘧原蟲,再將結果回傳,讓病人即時獲得治療。

▲瘧疾專家郭明珠指出顯微鏡下遭瘧原蟲寄生的紅血球。(圖/記者季相儒攝)
「看顯微鏡很枯燥,但顯微鏡下的世界卻很有趣。」郭明珠分享,引起人類感染的瘧原蟲包括惡性瘧原蟲、間日瘧原蟲、卵形瘧原蟲與三日瘧原蟲等,台灣常見的瘧疾種類為惡性瘧與間日瘧兩大類,過去比例為5:5,近年來惡性瘧有逐年增多趨勢,比例上升為6:4。
郭明珠稱,惡性瘧與間日瘧最大差異,在於發病時間,前者只要一天,後者則要48小時,一旦沒有及時治療,可能會產生腦炎、呼吸困難、腎臟功能衰竭等危機。
判讀血中瘧原蟲經驗豐富,郭明珠面對顯微鏡下的影像亦能侃侃而談。她指著影像檔表示,「間日瘧的名字取得很好。間日,也就是隔天,被叮了要隔一天才會發病。」而間日瘧原蟲喜歡寄生在幼小、年輕的紅血球,讓血球膨脹產生「許氏斑點」,也成了判讀上最大特徵;惡性瘧則不分紅血球期別全面寄生,「你看血球上面一個一個小黑點,就是瘧原蟲的指環體,嚴重感染的病人,一片血片上可揪出上萬、甚至破億隻瘧原蟲。」

▲惡性瘧不挑血球,感染患者一個血片最多能揪出上億隻瘧原蟲指環體。(圖/疾管署提供)
台灣瘧疾根除後,防疫重點從撲瘧、抗瘧轉為防守階段「保全期」,原本的瘧其研究中心也逐漸縮編,從百人單位減為10多人組室,至一業務單位,由郭明珠獨挑大樑。
隨著郭明珠退休日子逼近,疾管署苦於後繼無人,決定放手一搏,與人工智慧實驗室合作,利用AI揪出瘧原蟲,1月至今已用電子顯微鏡掃描了50片血片,標示出3000張瘧原蟲,交由機器進行圖靈測試,而郭明珠在過程中,除了協助分辨瘧原蟲外,也擔任圖靈測試主角,與人工智慧一決高下。
郭明珠表示,在研判上最大的不確定性,多為受到血小板與染色雜質干擾,原蟲構成要素主要有核、細胞質、色素三要件,通常血球會成不規則狀,若發現血球成「正圓形」那就要排除可能;此外,最常被誤認的血小板,也因為結構鬆散,會請同仁排除。
▲遭間日瘧原蟲寄生的紅血球會產生「許氏斑點」,也成了研究員的判斷依據。(圖/疾管署提供)
經歷過舊顯微鏡時代,新型電子顯微鏡讓郭明珠工作越發得心應手,拿到影像檔到揪出原蟲,最快只要3秒鐘。但郭明珠笑著補充,「這個速度僅限帶蟲數多的案例」,如果第一時間找不到,檢驗工作就如同大海撈針,最常需花上2至3小時。
郭明珠回憶當年受訓時,長官總是在一旁盯著看,「我看一小時,他就在我旁邊站一小時。」但她並沒有把同樣方式帶到後進同仁訓練中,每當後輩在判讀上遇到困難,她都會發揮專業,熱心解說。近年來台灣每年約有10至30例境外移入瘧疾個案,為了在第一時間幫患者投藥,郭明珠就算遇到下班時間,也得趕回實驗室開機判讀。在臨界退休的7月初,她依然為了臨時送來的印度漁工案例,在實驗室埋首加班。

▲疾管署2005年出版台灣瘧疾根除40週年手冊,郭明珠與冊中50多歲的自己合影。(圖/記者季相儒攝)
退休在即,面對人工智慧強勢崛起,郭明珠樂見其成。她直言不諱表示,AI判讀是未來趨勢,但機器需要人類教導,只要建好大數據資料庫,改由機器判讀無不可行。
但被問到未來機器是否有望完全取代人類?郭明珠依然對自己的專業有信心,「大陸也有AI,也沒有辦法做到百分之百。」就算大數據建置完成,還是需要靠人力做最後把關。她已把畢生經驗傳承給2位同仁,退休後若真的有需要,也不排除回鍋幫忙,揪出難辨瘧病。









讀者迴響